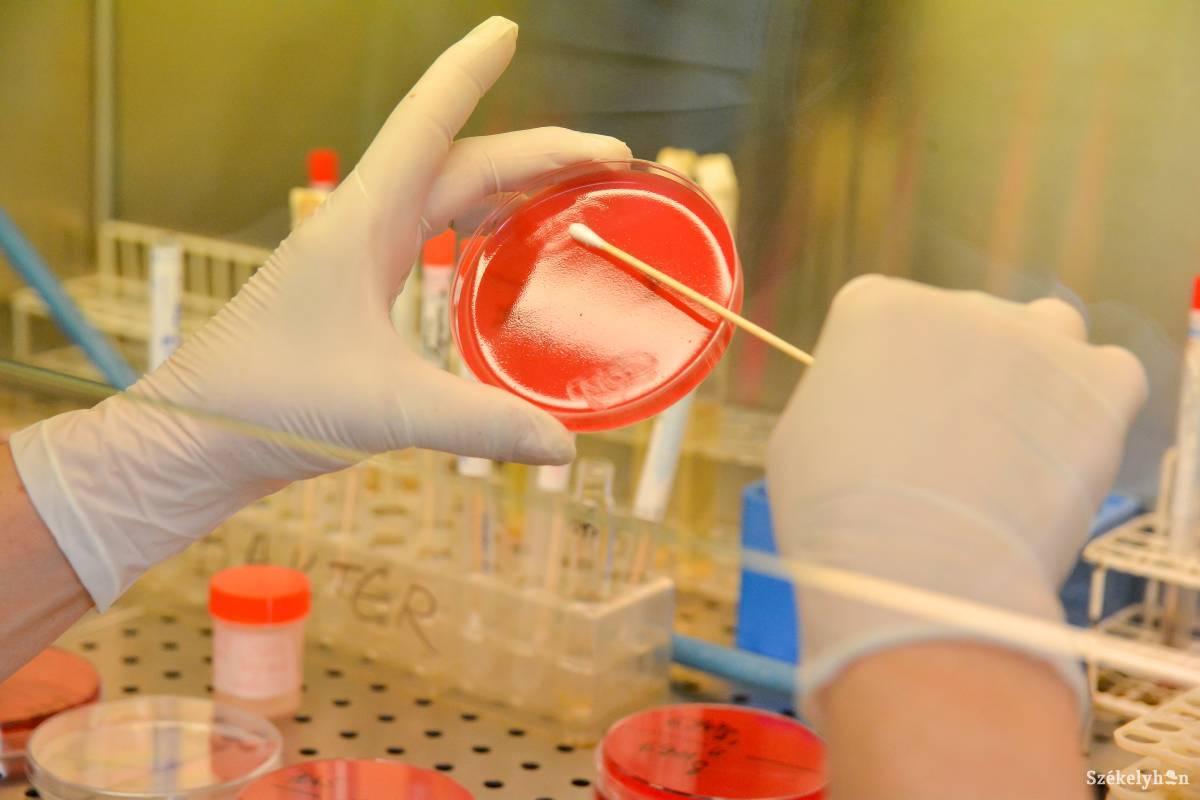
• Fotó: Mihály Csaba

A Prodia fogja végezni a laborvizsgálatokat
Fotó: Mihály Csaba
A rövid hercehurca után eldőlt: továbbra is a Prodia Kft. végezheti a Csíkszeredai Megyei Sürgősségi Kórház bennfekvő és sürgősségre beutalt pácienseinek laboratóriumi vizsgálatait – tudtuk meg a közbeszerzési eljárás eredményét Szabó Sándortól, a Prodia ügyvezetőjétől.
Molnár Rajmond
2016. március 10., 19:212016. március 10., 19:21
2016. március 10., 19:422016. március 10., 19:42
Mint Szabó közölte, szerdán kapták meg az értesítést, hogy győztesként kerültek ki a laborvizsgálatokért folytatott közbeszerzési versenyből. A Prodia mellett a – március 3-tól a kórháznak ideiglenesen laborszolgáltatásokat nyújtó – bukaresti Medcenter cég jelentkezett a közbeszerzési eljárásra.
„Amennyiben nem lesz fellebbezés a másik fél részéről, e hónap 22-én kell megkötnünk a három évre szóló szerződést. Ettől fogva a kórház határozza meg, hogy melyik dátumtól igényli újra a szolgáltatásainkat” – magyarázta Szabó. Ennek ellenére – fűzte hozzá – a Prodia megteszi a feljelentést a kórház ellen, mivel szerintük a megyei egészségügyi intézet testülete nem tartotta be közbeszerzések lebonyolításának előírásait.
Demeter Ferenc, a Csíkszeredai Megyei Sürgősségi Kórház menedzsere megkeresésünkre elmondta, a versenytárgyalás lebonyolítása során törvényesen jártak el, és már e hónapban érvénybe léphetnek a Prodia Kft. szolgáltatásai. „Amíg nem kötjük meg az új szerződést, továbbra is a Medcenter végzi a laboratóriumi vizsgálatokat” – tette hozzá. „Ez egy átmeneti időszak volt, ugyanis a bukaresti vállalat gyakorlatilag a 28 óra alatt a semmiből csinált laboratóriumi szolgáltatásokat. Mivel a Prodia elutasította a szerződés határidőn belüli meghosszabbítását, ezért kerültünk ebbe a helyzetbe, hogy ilyen kényszermegoldáshoz kellett folyamodnunk. Nekünk sem volt kényelmes éjjel két-három óráig dolgozni, hogy tudjunk laborszolgáltatást nyújtani, és ne keljen bezárnunk a kórházat” – magyarázta a kórházmenedzser.
Mint már arról beszámoltunk, nem hosszabbította meg március elsején lejárt szerződését a megyei kórházzal a Prodia vállalat. Bár a kórház vezetősége és a Prodia is meg akarta hosszabbítani a szerződést, utóbbi elfogadhatatlannak tartotta a kórház által felajánlott szerződésben foglaltakat, ezért hivatali visszaélés gyanújával készül feljelentést tenni az egészségügyi intézmény ellen. A visszás helyzet következtében, március 3-tól ideiglenesen a bukaresti Medcenter végzi az említett vizsgálatokat a kórház épületében nemrég felszerelt sürgősségi laboratóriumában.
Ezek is érdekelhetik
A rovat további cikkei
Idén még nem nyílik meg a bölcsőde Csíkszentsimonban
Noha jó ütemben dolgozik az építő és egy hónapon belül várhatóan befejezi a munkát, az ősszel kezdődő tanévben még nem tud gyermekeket fogadni a Csíkszentsimonban épülő bölcsőde. Számos tennivaló van még addig.

Idén még nem nyílik meg a bölcsőde Csíkszentsimonban
Elvégezték az első robotsebészeti műtéteket Csíkszeredában
Kevesebb vérveszteség, kisebb megterhelés és pontosabb beavatkozások – alig néhány héttel a Da Vinci-robot üzembe helyezése után már rendszeresen alkalmazzák a rendszert a Csíkszeredai Megyei Sürgősségi Kórházban.

Elvégezték az első robotsebészeti műtéteket Csíkszeredában
Útlezárásokra kell számítani szombaton Csíkszeredában az Ezer Székely Leány Napja miatt
Az Ezer Székely Leány Napja biztonságos lebonyolítása érdekében ideiglenes útlezárásokra kell számítani július 4-én, szombaton Csíkszeredában.

Útlezárásokra kell számítani szombaton Csíkszeredában az Ezer Székely Leány Napja miatt
Vérnyomok vezettek a több mint négyszázkilós medve teteméhez
Elpusztult az a nagyméretű medve, amely egy hónapja jószágokat pusztított Balánbányán, és csütörtök hajnalban ismét visszatért egy portára. A vadászok rálőttek az agresszív állatra, amely elmenekült, de reggel a vérnyomok alapján megtalálták a tetemét.

Vérnyomok vezettek a több mint négyszázkilós medve teteméhez
Közeleg az Ezer Székely Leány Napja, forgalomkorlátozásokra figyelmeztetnek a szervezők
Szombaton tartják Csíkszeredában az Ezer Székely Leány Napját. A hagyományőrző rendezvényt a Székely Népviselet Napja előzi meg, a szervezők pedig több forgalomkorlátozásra és biztonsági előírásokra hívják fel a figyelmet.

Közeleg az Ezer Székely Leány Napja, forgalomkorlátozásokra figyelmeztetnek a szervezők
A pozsonyi csata hőseire emlékeznek Csíkcsomortánban
A pozsonyi csata 1119. évfordulójára megemlékező ünnepséget tartanak pénteken 17 órától Csíkcsomortánban, a Kárpátok Őre emlékműnél.

A pozsonyi csata hőseire emlékeznek Csíkcsomortánban
Kivitelező lesz, de támogatás is kell a büdösfürdői beruházáshoz
Lezárult a közbeszerzési eljárás a Büdösfürdőre tervezett víz- és csatornahálózat kivitelezése érdekében a Csíkszentkirályhoz tartozó területet illetően. A munkálatok elkezdéséhez viszont a finanszírozás is szükséges.

Kivitelező lesz, de támogatás is kell a büdösfürdői beruházáshoz
Jávárdi-vízesés: a természet elvette, az emberek visszaadták – videó
Nem tétlenkedett a gyimesközéploki önkormányzat: mindössze három nappal azt követően, hogy egy áradás miatt megszűnt a Jávárdi-vízesés, sikerült visszaterelni a zuhatagot tápláló patakot a régi medrébe.

Jávárdi-vízesés: a természet elvette, az emberek visszaadták – videó
Főszerepben a lant: jubileumokkal és nemzetközi vendégekkel érkezik a Régizene Fesztivál
Jubileumok, nemzetközi fellépők, a lant kiemelt szerepe és generációkat összekötő mesterkurzusok várják a közönséget július 6–12. között a 46. Csíkszeredai Régizene Fesztiválon.

Főszerepben a lant: jubileumokkal és nemzetközi vendégekkel érkezik a Régizene Fesztivál
Rágcsálóirtás lesz Csíkszeredában
A rágcsálók szaporodásának megfékezése érdekében Csíkszereda Polgármesteri Hivatala közterületi irtást rendelt el.

















 Csíkszék
Csíkszék






 Látogatottsági adatok
Látogatottsági adatok
szóljon hozzá!